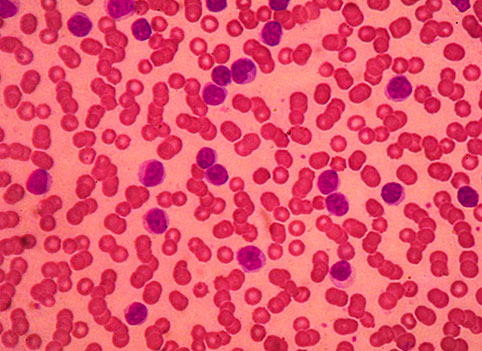

Заболеваемость
Хронический B-клеточный лимфоцитарный лейкоз (В-ХЛЛ) наиболее частый вид лейкоза среди населения западного полушария, показатель заболеваемости составляет 4 случая на 100 тыс. чел. в год. Заболеваемость возрастает почти до 30 случаев на 100 тыс. чел. в год в возрасте > 80 лет. Медиана возраста на момент диагностики составляет 69 лет; 14% пациентов моложе 55 лет.
Диагноз
Диагноз В-ХЛЛ может быть поставлен на основании следующих критериев: диагноз В-ХЛЛ требует наличия . 5000 B- лимфоцитов/мкл периферической крови на протяжении минимум 3-х месяцев. Клональность циркулирующих лимфоцитов должна быть подтверждена методом проточной цитофлоуриметрии.
Клетки В-ХЛЛ, определяемые в мазках периферической крови имеют облик малых лимфоцитов ― ядра содержат плотный глыбчатый хроматин, ядрышко не визуализируется, цитоплазма представлена узким ободком.
Клетки В-ХЛЛ коэкспрессируют Т-клеточный антиген CD5 и поверхностные В-клеточные антигены CD19, CD20 и CD23. Уровень экспрессии поверхностных иммуноглобулинов, CD20 и CD79b лимфомными клетками ниже, по сравнению с нормальными В-лимфоцитами. Каждый лейкемический клон отличается экспрессией только одного вида легких цепей иммуноглобулинов- каппы или лямбды.
Для сравнения, клетки лимфомы зоны мантии, отличаясь также коэкспрессией CD5 и В-клеточных поверхностных антигенов, как правило не несут молекулу CD23. Дифференциальный диагноз должен быть также проведен с лимфомой маргинальной зоны и иммуноцитомой.
В соответствии с определением, лимфома из малых лимфоцитов (ЛМЛ) характеризуется наличием лимфаденопатии и/или спленомегалии. Количество лимфоцитов в периферической крои не должно превышать 5х109/л. ЛМЛ имеют иммунофенотип, идентичный В-ХЛЛ. Диагноз ЛМЛ должен быть подтвержден морфологическим исследованием биопсии лимфоузла.
План обследования пациента перед началом терапии должен содержать следующие обязательные пункты [III, B]:
- анамнез и тщательный осмотр, включающий пальпацию всех групп периферических л/у;
- развернутый анализ крови с подсчетом формулы;
- биохимический анализ крови, включая уровень ЛДГ, билирубина и иммуноглобулинов сыворотки;
- прямой антиглобулиновый тест;
- определение инфекционного статуса, включая гепатиты В, С, цитомегалови рус и ВИЧ;
- рентген грудной клетки;
- УЗИ органов брюшной полости
Проведение пунктов, представленных ниже, является желательным перед началом специфического лечения [III, B]:
- Биопсия костного мозга не требуется для подтверждения диагноза. Биопсия КМ выполняется перед началом миелосупрессивной терапии или при возникновении цитопении неясного генеза;
- Определение цитогенетических аномалий, в особенности делеции короткого плеча хромосомы 17 (del 17p) посредством флуоресцентной in situ гибридизации (FISH) имеет значение для выбора терапии, поэтому исследование рекомендуется к проведению перед началом лечения.
- Проведение КТ-исследования рекомендуется для оценки эффекта при проведении клинических исследований [III,C], но не для рутинной практики за рамками протоколов.
Стадирование и прогноз
Медиана выживаемости от момента диагностирования варьирует от года до более 10 лет в зависимости от начальной стадии болезни. В настоящее время используются две системы клинического стадирования. В Европе в основном используются система стадирования по Binet, на основании которой выделяются 3 разные прогностические группы (таблица №1).
C появлением новых терапевтических возможностей, наметилось улучшение показателей общей выживаемости пациентов с продвинутыми стадиями В-ХЛЛ.
В настоящее время выделены факторы, позволяющие определять прогноз у пациентов уже на начальных стадиях. В-ХЛЛ с del(17p) (5-10% всех случаев) имеет наихудший прогноз и медиану выживаемости 2-3 года. Другой фактор плохого прогноза — del (11q), которая определяется примерно в 20% случаев. Негативное влияние del (11q) на прогноз может, однако, быть преодолено иммунохимиотерапией с применением флударабина, циклофосфамида и ритуксимаба (FCR) (см. ниже).
Мутация IGHV (генов, кодирующих вариабельные участки тяжелых цепей иммуноглобулинов) отсутствует примерно в половине случаев В-ХЛЛ. Эти пациенты отличаются достоверно менее продолжительной общей выживаемостью и коротким временем до начала терапии.
Экспрессия CD38 и ZAP70 коррелирует в определенной степени с мутационным статусом IGHV. В отличие от молекулярных аномалий, определяемых FISH, данные факторы, однако, не должны влиять на выбор терапии, поскольку их значение еще должно быть установлено в клинических исследованиях [III, C].
Лечение начальных стадий
К начальным относятся бессимптомные А и В стадии по Binet и 0, I и II стадии по Rai.
Стандартное лечение пациентов на ранних стадиях заболевания состоит в наблюдательно- выжидательной стратегии («watch and wait») под контролем анализа крови и проведении осмотра пациента каждые 3-6 месяцев [I,А].
Лечение должно быть начато при появлении признаков прогрессирования/активирования болезни, указанных ниже.
Лечение распространенных стадий заболевания (стадия по Binet А и В с симптомами активного процесса, Binet стадия С; стадия по Rai 0II с симптомами, Rai стадии IIIIV)
Лечению подлежат пациенты при наличии следующих признаков активации болезни: выраженные В-симптомы, цитопения, не являющаяся следствием аутоиммунных нарушений; осложнения, вызванные увеличением лимфатических узлов и сплено/гепатомегалией, а также больные с аутоиммунными анемией и тромбоцитопенией, плохо поддающимися терапии стероидами [I,A].
Соматическая сохранность и отсутствие тяжелой сопутствующей патологии должно лежать в основе выбора терапии.
Для начальной терапии соматически сохранных больных (физически активны, без серьезной сопутствующей патологии, с сохранной почечной функцией) терапией выбора служит схема FCR. Данный режим считается стандартом первой линии, поскольку, как было показано недавно, существенно влияет на улучшение показателей выживаемости [II,A]. Для соматически отягощенных пациентов, терапия хлорамбуцилом в первой линии остается стандартом лечения [II, B]. Альтернативой могут служить режимы на основании пуриновых аналогов в редуцированных дозах [III, B] или бендамустин [II, B].
Пациенты носители делеции 17р часто оказываются резистентны к стандартным режимам химиотерапии (монотерапии флударабином или комбинации FC). Введение в практику химиоиммунотерапии (FCR), также не повлияло на показатель безрецидивной выживаемости, которая остается непродолжительной. Таким образом, при наличии del(17p) должна быть предложена трансплантация аллогенных стволовых клеток в первой линии в рамках протоколов клинических исследований [III, B].
Вторая линия химиотерапии
Первая линия терапии может быть проведена повторно, если рецидив или прогрессирование развились более чем через 12 месяцев от начального лечения или спустя 24 месяца после иммунохимиотерапии [III, B].
Если рецидив развился в течение 12 месяцев от начального лечения или в течении 24-х месяцев после иммунохимиотерапии, а также при отсутствии эффекта от терапии первой линии, рекомендовано использование следующих препаратов и/или комбинированных схем:
- Алемтузумаб-содержащие режимы с последующей аллогенной трансплантацией для соматически сохранных пациентов
- FCR для пациентов резистентных или в рецидиве после терапии первой линии
- Алемтузумаб или бендармустин–содержащие режимы для соматически сохранных пациентов при отсутствии del(17p). В данной группе также возможна попытка применения офатумомаба или ритуксимаба в высоких дозах в сочетании со стероидами
- Алемтузумаб для пациентов- носителей del(17p).
Для достижения лучшего эффекта у пациентов с большой опухолевой массой, алемтузумаб может быть комбинирован с флударабином или стероидами.
Аллогенная трансплантация стволовых клеток является единственным методом излечения больных группы высокого риска (наличие del (17p) или del (11q)), а также во всех случаях рефрактерного течения болезни.
Аутологичная трансплантация стволовых клеток не показала преимущества в сравнении с современной иммунохимиотерапией и не должна более рассматриваться как терапевтическая опция при В-ХЛЛ [III, B].
Примерно в 10% случаев (3-16%) В-ХЛЛ развивается Синдром Рихтера, который представляет собой трансформацию в крупноклеточную лимфому, Лимфому Ходжкина или пролимфоцитарную лейкоз (ПЛЛ)***. Прогноз при Синдроме Рихтера, также как и при В-ПЛЛ очень плохой. Полихимиотерапия в сочетании с моноклональными антителами может быть предметом выбора, однако лечение, как правило, не приводит к получению длительных ремиссий.
Аллогенная трансплантация представляет собой экспериментальный подход, который, однако, может быть использован у соматически сохранных пациентов с Синдромом Рихтера.
***Синдром Рихтера представляет собой исключительно трансформацию В-ХЛЛ в диффузную В-клеточную крупноклеточную лимфому (прим. переводчика).
Оценка эффекта
Оценка эффекта лечения основана на контроле клинического анализа крови и тщательного осмотра пациента.
Исследование костного мозга показано только при достижении полной гематологической ремиссии.
Проведение рентгенологического исследования органов грудной клетки, ультразвукового исследования или компьютерной томографии органов брюшной полости для оценки эффекта проведенной терапии показано только в случае наличия регистрации изменений теми же методами перед началом лечения [V,D]. Определение минимальной резидуальной болезни (MRD) при помощи 4-х цветной проточной цитофлоуриметрии имеет прогностическое значение для длительности ремиссии. Пациенты с негативной MRD по окончании терапии обладают достоверно более длительной продолжительностью ответа. Клиническое значение негативной MRD однако до конца не ясно, поэтому анализ MRD имеет значение только в рамках клинических исследований, но не в рутинной практике.
Наблюдение
Наблюдение пациентов при отсутствии симптомов заболевания должно включать клинический анализ крови каждые 3-6 месяцев и тщательный регулярный осмотр лимфоузлов, печени и селезенки.
Особое внимание следует уделять появлению аутоиммунных цитопений (аутоиммунная гемолитическая анемия, аутоиммунная тромбоцитопения), встречающихся у 10-15% больных В-ХЛЛ.




